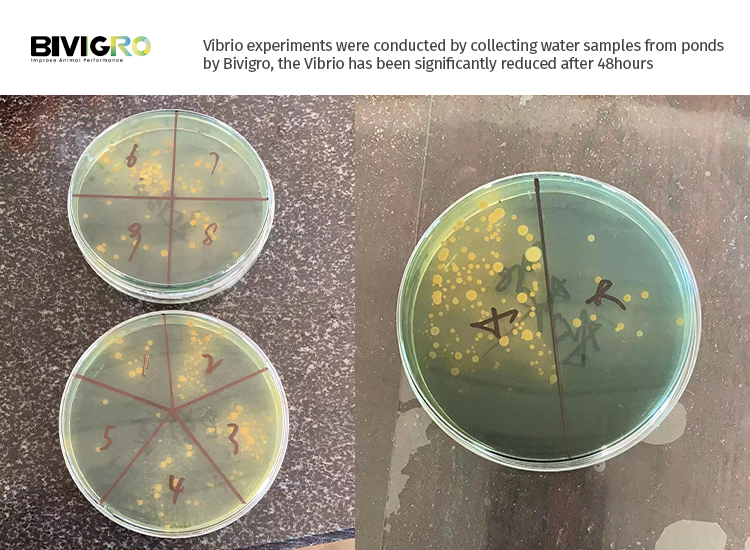

-
Company
-
Products
-
Events
-
Feed Talk
-
Contact
-
Follow Us
How to Control Vibrio In Aquatic Pond Water
Vibrio species, particularly V parahaemolyticus and V harveyi, pose severe threats to global shrimp aquaculture b
Vibrio species, particularly V. parahaemolyticus and V. harveyi, pose severe threats to global shrimp aquaculture by causing devastating diseases such as Early Mortality Syndrome (EMS) and Vibriosis. These pathogens trigger rapid shrimp mortality rates of 70–100% within days of infection, leading to massive economic losses for farmers. Traditional control methods, including antibiotics and chemical disinfectants, have proven inadequate due to rising antibiotic resistance, environmental pollution risks, and residual toxicity that compromises shrimp quality and ecosystem health. Furthermore, Vibrio biofilms in ponds and shrimp intestines enhance their survival and virulence, making eradication even more challenging. These issues are critical for ensuring sustainable shrimp production and safeguarding global food security.

Based on such situation, We, Bivigro Animal Health Limited, has developed Vibrio Master, an advanced biological product designed to effectively combat pathogenic Vibrio species in shrimp aquaculture. Targeting major threats like V. parahaemolyticus and V. harveyi, which cause Early Mortality Syndrome (EMS) and Vibriosis, this solution perfectly solves one of the most pressing challenges in shrimp farming.
Vibrio Master adopted specifically selected metabolites from Clostridium butyricum to eliminate Vibrio through multiple pathways:
(1) In pond water, these metabolites create an unfavorable environment for Vibrio by releasing organic acids (including butyric acid) and especially bacteriocins, which disrupt bacterial cell membranes and metabolic functions. Additionally, the probiotic metabolites breaks down Vibrio biofilms, enhancing exposure and eradication efficiency.
(2) Once vibrio master fed and enter the intestine of shrimp, the metabolites colonize in the intestinal tract, competitively excluding Vibrio from nutrient sources and adhesion sites. This gut microbiota modulation reduces Vibrio colonization while stimulating the shrimp’s immune system, increasing antimicrobial peptide production and overall disease resistance.
Extensive field applications confirm Vibrio Master’s ability to reduce Vibrio populations by 90–95% within 48 hours, significantly lowering disease-related mortality. Treated ponds demonstrate 70–80% higher survival rates during outbreaks, along with improved growth performance and feed conversion efficiency.
Stands out as a reliable biological agent for Vibrio control in shrimp farming, the Vibrio Master can be suitable for a wide range of environmental conditions. Unlike conventional treatments that often fail under fluctuating water parameters, Vibrio Master operates effectively in pH levels ranging from 6.5 to 8.6 and water temperatures between 12°C and 37°C, making it suitable for both tropical and subtropical regions. Moreover, it performs consistently in both freshwater and seawater systems, easy use which just adding into water and splash into pond, or mix it into feeds for shrimp feeding, addressing the needs of diverse aquaculture setups worldwide.
The product’s natural solution ensures safety for shrimp, beneficial bacteria, and the environment, avoiding the risks of chemical residues or antibiotic resistance. Its dual application method either directly dosed into water or mixed with feed provides flexible and comprehensive protection.
